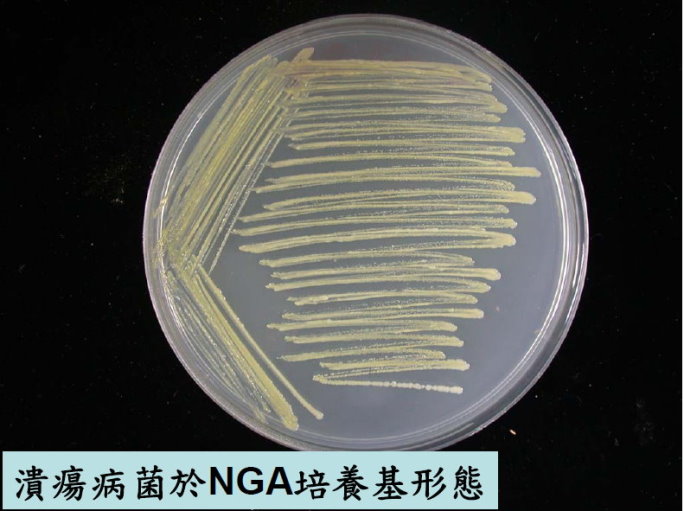
潰瘍病菌於NGA培養基形態

收件日期:990108
發生地點:臺東縣泰源鄉北源村
病蟲害名稱:柑桔潰瘍病
病徵判斷
*柑桔潰瘍病
◎ 由Xanthomonas axonopodis pv. citri引起之潰瘍病,可感染多數柑桔類作物如葡萄柚及檸檬等。
◎ 潰瘍病議會發生在晚生橙、臍橙廣東檸檬及萊姆等植株上,由得病植株作長時間及遠距離的傳播。
◎ 潰瘍病菌受到如暴風及豪雨等外在環境之刺激可增加其傳播速度及嚴重程度。
防治方法
*田間衛生:果園內環境應保持清潔,清除及燒燬感染柑桔潰瘍病枝條及葉片以防止潰瘍病菌大規模擴散傳播。
*種植防風林:栽植防風林,以阻隔風雨吹襲,造成柑桔潰瘍病之發生。
*藥劑防治:
◎ 10%維利黴素溶液800倍
◎ 72%波爾多可濕性粉劑500倍
◎ 56%氧化亞銅可濕性粉劑600倍
◎ 81.3%嘉賜銅可濕性粉劑1,000倍
◎ 10%鏈四環黴素可溶性粉劑1,000倍



